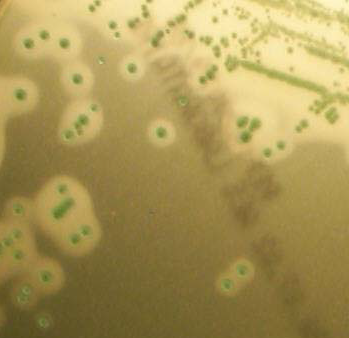

Листерия погибает
Лучшие проекты дома до 150
Школу номер 89 город
Маленький мальчик который поет
Расписание автобусов гатчина варшавский кубус
Праздник приноси много радости
Мелитополь 2025 фото
Error compiling movie
Госуслуги как получить торт
Размеры лонжерона нивы
Бесплатные говорящие рингтоны на звонок
Проблемы движущих сил психического развития
Evolution of life game
Радиатор алюминиевый fondital
Листерия погибает 112 фото